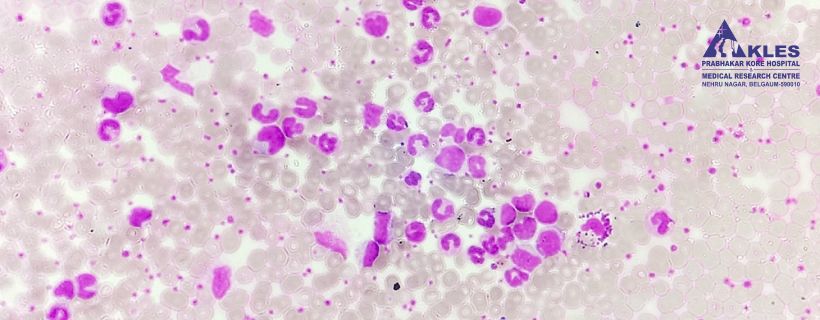
Thrombocytosis

Medically Reviewed by Dr. Prashant Rathod, General Medicine
Written by KIE Editorial Contributors
3.5 min read | Published On: 13-10-2025
Thrombocytosis is a condition where your blood has too many platelets (more than 4,50,000 per microliter of blood). Usually, the normal range for a platelet count is 1,50,000 to 4,50,000 platelets per microliter of blood.
A count below 1,50,000 is considered low, and a count above 450,000 is high. Platelets are tiny cells in your blood that help it clot. They stop bleeding when you get a cut or injury.
While it might sound worrying, having extra platelets does not always mean something is seriously wrong. Sometimes, thrombocytosis is temporary and resolves on its own. Other times, it may indicate an underlying condition that needs care.
Understanding what thrombocytosis is, why it happens, and how it is treated can help you feel more in control. Asking questions and working closely with your healthcare team is the best way to stay safe and healthy.
Thrombocytosis is not a single condition. It can arise from different causes, broadly classified into two main types. Knowing the kind helps doctors diagnose accurately and plan the proper treatment.
Reactive thrombocytosis, also called secondary thrombocytosis, is usually temporary. It happens because your body is reacting to another condition. Common reactive thrombocytosis causes include:
Once the underlying cause is treated, platelet counts usually return to normal. Your doctor may order follow-up blood tests to ensure your platelet levels stabilize.
Essential thrombocytosis is a chronic condition where the bone marrow produces too many platelets without a clear cause. Diagnosis may include:
Essential thrombocytosis often requires lifelong monitoring. In many cases, medication is needed to reduce the risk of complications.
Thrombocytosis often develops without noticeable signs, but some people may experience symptoms related to abnormal clotting or bleeding. Recognizing the symptoms of thrombocytosis is essential for early detection and timely treatment.
Common thrombocytosis symptoms include:
Symptoms vary depending on whether the thrombocytosis is reactive or essential. Sometimes, thrombocytosis is discovered during routine blood tests, before any symptoms appear.
If you also have anemia with thrombocytosis or leukocytosis, your doctor may suggest additional tests to determine the cause and guide treatment.
Thrombocytosis can develop due to temporary reactions or chronic blood disorders. Knowing the cause helps guide treatment.
Causes are divided based on the type:
Understanding the cause helps your doctor decide if treatment is needed and what type will be most effective. Sometimes, identifying the cause can take a few blood tests and follow-ups.
Most people with thrombocytosis do not develop serious complications, especially if treated promptly. However, high platelet counts can sometimes increase risks, including abnormal clotting or bleeding. Understanding these potential complications is essential for timely management and prevention of serious health issues.
Possible complications include:
Regular monitoring and treatment can greatly reduce these risks. Your doctor will guide you on how often to get blood tests and what warning signs to watch for.
Doctors diagnose thrombocytosis using a combination of blood tests and sometimes other examinations:
Diagnosis helps determine the type of thrombocytosis and the best treatment plan.
Treatment depends on the type of thrombocytosis, the cause, the severity of symptoms and overall health. Early management helps prevent complications.
Even if medication is needed, most people with thrombocytosis can live a normal, active life.
Managing thrombocytosis means staying aware and proactive:
Living with thrombocytosis is about balance, careful monitoring, while continuing daily life safely.
Knowing when to seek medical help is crucial for anyone with thrombocytosis. While many people experience no symptoms or only mild effects, certain warning signs can indicate a serious complication that requires prompt attention. Being aware of these signals can help you get timely treatment and reduce the risk of blood clots, excessive bleeding or other health problems.
Seek medical care immediately if you notice:
Early attention can prevent complications and ensure timely treatment.
Get in Touch with a Doctor
Yes, reactive thrombocytosis often resolves once the underlying cause, like infection, inflammation, or iron deficiency, is treated. Essential thrombocytosis usually requires ongoing monitoring and care.
Thrombocytosis is a higher-than-normal platelet count, increasing clotting risk, while a low platelet count (thrombocytopenia) raises bleeding risk. Both affect clotting but need different management.
A balanced diet rich in fruits, vegetables, whole grains, and lean protein supports overall health. Avoid smoking and excessive alcohol. No specific foods alone can lower platelet counts.
Frequency depends on type and severity. Reactive cases may need occasional checks, while essential thrombocytosis usually requires regular monitoring to track platelet levels and prevent complications.
Yes, children can develop reactive thrombocytosis, often due to infections or inflammation. Essential thrombocytosis is rare but may require long-term follow-up and monitoring if diagnosed.
Avoid activities with a high risk of cuts or injuries until your doctor advises. Safe exercise and daily activities can usually continue with guidance, but caution is recommended to reduce bleeding or clotting risks.